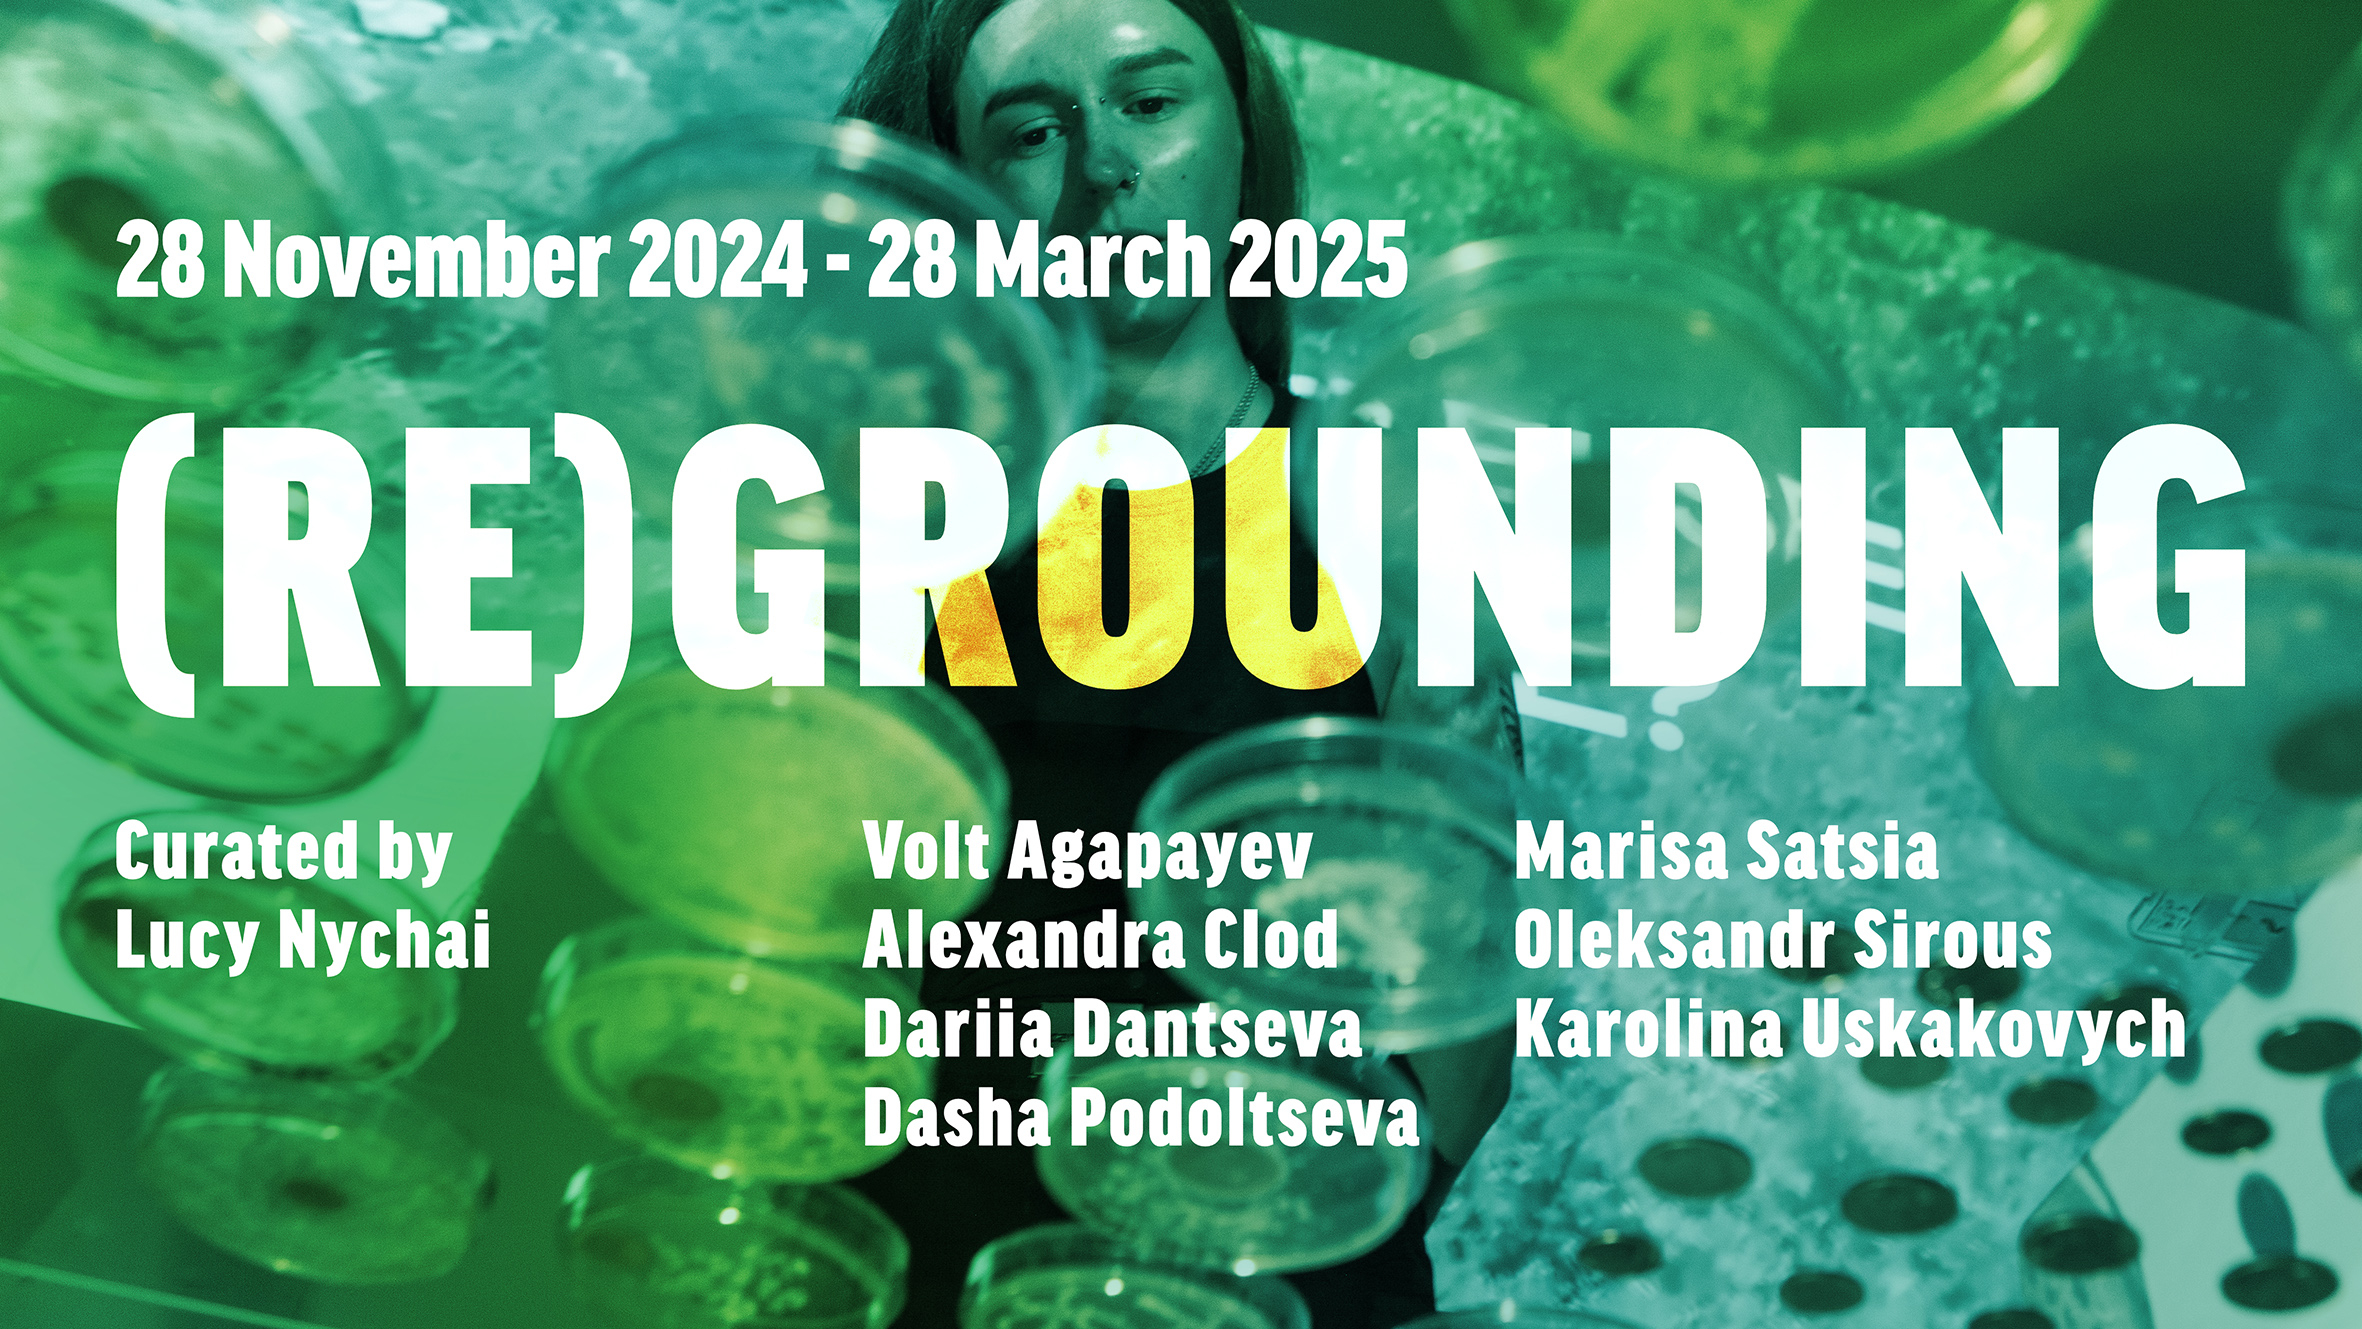
Video

LUCY NYCHAI
art practitioner, researcher
I feel that my vocation is to stimulate the use of artistic interventions and interactions, in order to encourage a responsible ecosystem of artists and society as a whole. In particular, the ongoing evolution of technology that supports and builds new humanity connecting ancient knowledge with future technologies.
In my curatorial, artistic, and social practices, I always look for the perfect balance between them.
About
Lucy Nychai/ Liudmyla Nychai
Art practitioner, artist, researcher, curator and teacher. Works with the topics of memory and commemoration, sustainable ecosystems, and site-specific projects, and studies ethical issues of digital art.
Co-founder and project curator of Nazar Voitovich Art Residency (NVAIR), Curator of the international program of virtual art residencies Artist is Absent.
Co-founder and Project Coordinator of the NGO Congress of Culture Activists.
Associate Artist of D6:Culture in Transit, Newcastle, 2023-2026The curatorial and artistic practices are intricately intertwined in her work, with themes that Lucy explores being deeply social and reacting to the turbulence of political life in Ukraine. The revolution, the onset of war, the pandemic, and the full-scale invasion serve as catalysts for her reflections, touching on various related issues: commemoration, cultural heritage, decolonisation of narratives, social ecosystems, focused on digital ones, as well as on social and environmental justice.Lucy researches international practices of art residencies and their impact on local and global cultural policies. Facilitator of the Active Citizens program of the British Council. For 2 years, she worked in a team of brand developers for communities in the so-called "grey zone" of Luhansk and Donetsk regions within the framework of the UN project. She's researched the cultural identity as a potential for territorial development.
Has a year-long practice of the curatorial residency program at D6: Culture in Transit, Newcastle, UK
Get in touch!
EDUCATION AND FURTHER STUDIES:
31/08/1998 – 24/06/2004 – Ternopil Volodymyr Hnatiuk National Pedagogical University, Ternopil, Ukraine
1998-2003 - Specialist Degree in Primary Education and Fine Art
2003-2004 - Master of Education Science. Fine Art Teacher/ The programme focused on the methodology of shaping artistic practice, technique mastery and creative thinking./ Thesis focused on the analysis of the practice of the local Artistic Union on the edge 19rh and 20th centuries.
Trainings, Courses and Study Visits:
18/10/2024-7/03/2025 - Climate Adaptation for Creatives Course - British Council and Black Mountains College, online. Certificate of Completion
20-29/08/2023 - Women in Conflict 1325. Fellowship Programme ‘The Arts as a Tool for Peacebuilding’ - Beyond Borders Scotland, Edinburgh, UK. Certificate of Completion
30/11/2020 – 14/01/2021 Basics of Marketing Course - Projector school, Ukraine. Certificate of Completion
30/04 - 22/05/2020 - Culture and Politics: the ambiguity of interrelationships Course - Prometheus - School for Policy Analysis, Ukraine. Certificate of Completion
18/01/2019 – 25/01/2019 – Active Citizens. International Study Visit - British Council. London, Hull, UK - Certificate of Completion
16/09/2016 – 24/09/2016 – ‘Together and Learning from each other»: Exchange of experiences between cultural figures’ Study visit - Goethe Institute, Essen, Germany.
08/2015 – Communication theory of cultural projects. Workshop - Goethe Institute/ NGO Congress of Cultural Activists. Kyiv, Ukraine.
18/09 - 12/12/2002 - Digital Design Course - Ivan Pulyuy Ternopil State Technical University, Ternopil, Ukraine - Certificate of Completion
Curatorial Experience
2025 (August-November) - Curator of online programme of art residency within DATAS project, implemented by Projekt Atol (Slovenia), Goethe-Institut (Germany), IZOLYATSIA (Ukraine), MeetFactory (Czech Republic), and Tallinn Art Hall (Estonia). https://izolyatsia.org/en/project/datas
2024 (March-August) - Programme Curator and Exhibition Curator of ‘KUT 772’ - Architectural and artistic research residence, Kharkiv and Ternopil regions, Poltava, Ukraine https://kut777.framer.website/project
2024 (June-October) - Art residency curator (D6’s curator in residence) and Digital Exhibition Curator of ‘(Re)Grounding 2024’. Programme which connecting artists with heritage and environmental partners, the next phase of (Re)Grounding journeys from Ukraine to Cyprus and the UK.
2023 - Curator of online art residency project ‘Grounding. Invasion’, Izolyacia Foundation, online Ukraine https://izolyatsia.org/en/project/ zazemlennia-invasion
2022 - 2023 - Art residency curator of (Re)Grounding Project, wich explores the climate emergency in post-industrial contexts through a residency programme connecting artistic practice, heritage and communities in the UK and Ukraine. Exhibition at The New Bridge Project, Newcastle, UK https://www.d6culture.org/regrounding.html
2018 - Guest Curator (Ukrainian projects) of gallery and projectarium Lite-Haus, Berlin, German
2017 - 2022 - Programme Curator, co-founder International Art Residency - NVAIR, Zbarazh, Ukraine. https://nvair.art/en/programms/
2010 - 2012 - Programme Curator of privat gallery ‘Art Space 365’, Kyiv, Ukraine
Independent Curatorial Practices:
2024 - Exhibition Curator ‘50 heads and some bodies’ - Collaboration Lucy Nychai with Graham Robinson and PaulShpil, Queens Hall Gallery, Hexham, Northumberland, UK
2024 - Exhibition Curator ‘Lost&Found’ - Cross Arts Ukrainian/Tynedale Artists Collaboration, Queens Hall Gallery, Hexham, Northumberland, UK https://tsf.org.uk/seed
2024 - Project and Exhibition Curator ‘Resettlement’ - Pou-Up artist residency program and group exhibition AUTONOMY + DIGNITY, Lite-Haus Gallery, Berlin, Germany https://www.lite-haus.net/autonomy-dignity
Recent Art Exhibitions
2026 - "Growing through the cracks" at Koyodai, Inagi City, Tokyo. The Showcase part of Black Sheep Project.
2025 - "Unresolved Landscapes" Marginal Art Fair, Fukushima Hirono, Japan. The Showcase part of Black Sheep Project.
2025 - "Growing through the cracks" - Ukrainian exhibition at the Tokyo Catholic University, Japan. The Showcase part of Black Sheep Project.
2024 - “Warm practices” - group show, City Library, Newcastle, UK / (ceramic)
2024 - “Lost and Found”, QH Gallery, Hexham, UK / Black Sheep Project (embroidery)
2024 - “Autonomy+Dignity”, Lite-Haus Gallery, Berlin, Germany / “Resettlement” (Ink on paper)
2023 - “Nomads” - Black Sea Festival, Timisoara, Romania / System of Defence (objects, epoxy resin, fallen leaves)
2023 - “Cry of the Nightingale” Personal show - Orr Gallery, Auchmithie, Arbroath, Angus, Scotland (Ink on paper, storytelling)
See older projects here https://lucynychai.carrd.co/#atrtictic
PRESENTATIONS AND PARTICIPATION IN INTERNATIONAL CONFERENCES:
2025 TransCultural Exhange Conference. Panelist, Boston, USA (IRL)
2024 Kut 772. Treasures. Future of heritage. Speaker. Poltava, Ukraine (IRL)
2024 In conversation session on enforced mobility and displaced artists. Speaker. ON THE MOVE Cultural Mobility Forum 2024, Wales (IRL)
2024 How to Inhabit Instability: Showcase of Ukrainian Art Residencies. A Res Artis regional meeting with Ukraine, Speaker, (online) February
2023 ONE YEAR ON: Building Solidarity in the creative sector. Speaker, Birmingham, UK (IRL)
2023 Focus Europe. Speaker, Fraising, Germany (IRL)
2022 TransCultural Exhange Conference. Panelist, Boston, USA (IRL)
2021 Res Artis Conference. Panelist, Bangkok, Thailand (online)
2021 Digital Art Mobility Conference. Moderator, Ukraine (online)
2020 The end of the Grand Tour? Speaker, Mexico (online)
HONOURS AND GRANTS:
2025-2026 Individual grant. Climate Adaptation Creative Grant from British Council// Personal project «Good Intention» - animated graphic novel. UK
2023-2024 Individual mobility grant for cultural and art practitioner «EU4Culture» // Personal project «Resettlement», pop-up group art residence, empirical research of migration, Berlin, Germany
20-29/08/2023 Fellowship holder of the Beyond Borders Scotland, Women in Conflict 1325. Fellowship Programme «The Arts as a Tool for Peacebuilding», which took place in Edinburgh, UK
31/10/2022 Scholarship holder of the program of emergency assistance for cultural workers from Ukraine from the Goethe Institute // Presentation of curatorial art projects abroad (Germany and the UK)
02/12/2020 Individual grant House of Europe // Opportunities Networking and learning experience of the online art residency programs. Global Digital Art Mobility Conference 2021 supported by Res Artis.
11/07/2019 Individual mobility grant for cultural manager/ First call – I-Portunus. // Individual research program in D6 Residence: Culture in Transit, Newcastle upon Tyne
CURATORIAL PRACTICE
Curator of the online art residency programme with Izolyatsia
within The DATAS (The Data and the Sovereign), Kyiv, Online
August - November, 2025

The DATAS (The Data and the Sovereign) is a residency program and a set of pop-up and final exhibitions initiated and implemented by Projekt Atol (Slovenia), Goethe-Institut (Germany), IZOLYATSIA (Ukraine), MeetFactory (Czech Republic), and Tallinn Art Hall (Estonia).Computation and automation are reshaping global political dynamics, challenging established sovereignties, and necessitating a fundamental shift in our understanding of politics. The rise of algorithmic influence on our decisions based on rapidly evolving AI technologies prompts questions about preserving personal and national sovereignties in a post-surveillance information society and the role of art in reflecting this shift.Co-funded by the European Union as part of the Creative Europe framework. Views and opinions expressed are howeverthose of the author(s) only and do not necessarily reflect those of the European Union or EACEA. Neither the European Union nor the granting authority can be held responsible for them.Co-funded by New Democracy Fund / Danish Cultural Institute.DATAS (2025-26) is an assembly convened to amplify unheard voices from Central and Eastern Europe, and Southern Caucasus, reflecting on the relationship between the self, technology, and power. Produced in partnership between Goethe-Institut (Germany), Izolyatsia (Ukraine), MeetFactory (Czech Republic), Projekt Atol (Slovenia) and Tallinn Art Hall (Estonia).
Curator of the project 'KUT 772’ - Architectural and artistic research residence,
Kharkiv and Ternopil regions,
Exhibition at Vasyl Krychevskyi Poltava Local Natural History Museum. Poltava, Ukraine
2024
KUT 772: Treasures is an architectural and artistic exploration and reflection on the intangible cultural heritage of two communities located 772 km apart. The project aimed to reveal the creative potential often buried under daily routines and overshadowed by the conditions of war. We set ourselves abstract goals: to discover, observe, listen, share experiences, gather impressions, and illuminate these findings through curatorial, artistic, and architectural practices.The team behind this pilot program of artistic and architectural research residency brought together an interdisciplinary group: a researcher of intangible cultural heritage, a curator of art projects, an architect-urbanist, an artist focused on identity studies, and an artist responding to social and geopolitical challenges through their work.Contributors to the project included:Iryna Kats – researcher,
Lucy Nychai – curator,
Roksolana Dudka – artist,
Vartan Markaryan – artist,
Oleksandr Stolovyi – architect-urbanist."KUT 772: TREASURES" ExhibitionAs a result of the research, an exhibition was held in one of the halls of the Vasyl Krychevskyi Poltava Local Natural History Museum. The museum itself became a symbolic addition to the concept of preservation and renewal, as its main building has been closed for renovations since 2021. The museum's incredible walls added a unique atmosphere, while the freedom of the exhibition layout within the hall highlighted the significance of living intangible cultural heritage. The curator of the exhibition is deeply grateful to the museum team and the Department of Culture of the Poltava Regional Military Administration for their collaboration and support in bringing this exhibition to life.Together with curator Lucy Nychai, artists Roksolana Dudka and Vartan Markaryan, as well as architect and writer Oleksandr Stolovyi, created art objects as a continuation of their research, expressing impressions, concerns, and reflections on the past and the future.The foundation for these reflections was inspired by the creativity of both local and visiting artists and artisans. The exhibition featured a range of artefacts, providing an evidence base for the context of the Zbarazh and Krasnokutsk communities.Among the "Treasures" were original artefacts from the families of blacksmiths Myshchenko and beadwork master Halyna Mykhalska, abstract paintings by Serhiy Dekalyuk, and a documentary video by Svitlana Pohasiy capturing a Lemko folk song performed by Viktor Mandziuk.Additionally, works from the collection of the Nazar Voitovych Art Residency (2017–2022) were exhibited, including pieces by Oleksandra Pavlovska, Roksolana Uhryniuk, TkhT Group, and Volodymyr Shumylo.The exhibition also included works from the creative circle "Brothers" by Lyuba Popova, Olena Moiseenko, Olena and Anna Spiridonova, Vyacheslav Nikitchenko, and Oleksii Vasyliiev.The central installation consisted of adobe blocks crafted by Vyacheslav Nikitchenko using his own contemporary technology.Organizers: NGO Cultural Dialogue in collaboration with NGO Congress of Cultural ActivistsThe 'KUT 772' project is implemented by NGO Cultural Dialogue and co-financed by the ZMINA: Rebuilding program, created with the support of the European Union in Ukraine as part of a special call for proposals to support Ukrainian displaced persons and the Ukrainian cultural and creative sectors, with assistance from IZOLYATSIA. Platform for Cultural Initiatives, Trans Europe Halles, and Malý Berlín.
Curator of the programme - (Re)Grounding 2024
D6: Culture in Transit, on-site art residency and Digital Exhibition
28 November 2024 - 28 March 2025
(Re)Grounding artists: Volt Agapeyev, Alexandra Clod, Dariia Dantseva, Dasha Podoltseva, Marisa Satsia, Oleksandr (Alex) Sirous and Karolina Uskakovych
Collaborating artists: Alexey Shmurak and Matthew O’Toole
Curator: Lucy Nychai(Re)Grounding is an urgent call to build solidarity towards environmental justice through artistic production and community exchange.Over the past two years, the participating artists have been seeking answers to environmental challenges during residencies with D6 in Cyprus and the UK and with IZOLYATSIA in Ukraine, drawing threads between the histories shared between their homeland and communities of the mining areas of Lefke and Skouriotissa in Cyprus and the North East of England.Their artworks are presented together in an online exhibition. Taking the artists’ research and responses to create a journey: beginning deep in the earth, moving to extraction and invasion, then to gardening and finally looking to the future.Each artist brings a unique perspective, expressing their findings through their chosen mediums. They respond with poetry, performance, experimentation, film and photography, incorporating collaboration, science and technology.The projects investigate the impact of industrial activity on the environment, with a particular emphasis on the effects of war, which has left its mark on both the artists and the programme itself. Originally, the programme was set to launch in the city of Soledar, eastern Ukraine - a city now physically destroyed and occupied by Russian forces.
Not only do they confront contemporary challenges but they envision potential solutions for the future of Ukraine and a socially just green transition for us all.
(Re)Grounding is a partnership between IZOLYATSIA (Ukraine), D6:EU (Cyprus) and D6: Culture in Transit (UK).The programme is supported by: the UK/UA Creative Partnerships programme created by the British Council in partnership with the Ukrainian Institute; European Cultural Foundation; Arts Council England; the Paul Hamlyn Foundation; the Cyprus Department of Contemporary Culture of Deputy Ministry; the Goethe-Institut Zypern; the NewBridge Project; Vsesvit, and EKATE (Cyprus Chamber of Fine Arts).Homepage image: Dariia Dantseva and Marisa Satsia, Atomic Number 29, 2024. Photo: Andriana Lagoudes
Dariia Dantseva, Where is my Steppe? (seedbomber), 2024
Grounding. Invasion
Izolyacia Foundation, on-line Ukraine
2023
The online residency program Grounding. Invasion invites Ukrainian artists who work with any digital or analog media (sound, installation, photography, painting, video, research, etc.) and are ready to revise the consequences of aggressive military intervention, to pay attention to the ecological state of the country right now. The program will take place in an online educational and artistic format, consisting of a public discussion program with experts in the field of ecology and the post-industrial era, as well as an online residency during which four participants will develop their projects with curatorial and mentoring support. The program will result in an online presentation of art projects and their publication on the website.
(Re)GROUNDING
Exhibition of research of Karolina Uskakovych and Alexandra Clod
The New Bridge Project, Newcastle, UK

Journeying from the industrial landscapes of Ukraine to former coal mines and community gardens of the North East, artists Alexandra Clod (Krolikowska) and Karolina Uskakovych respond to the climate crisis by exploring the shared industrial past of the UK and Ukraine and its impact today.For the (Re)Grounding exhibition, Alexandra connects her grandfather’s mining heritage and the classical myths of the underworld to the story of coal and its extraction, while Karolina explores human-land relationships during times of war and industrial transformation through gardening.Casting light on the Anthropocene era - where human actions dictate our climate and environmental future, their message is a shared one: to understand where we are coming from in order to nurture the land and our planet and stop the damage that is being done.(Re)Grounding is co-produced by D6 and Kyiv-based IZOLYATSIA, with D6 curator in residence Lucy Nychai and is part of the UK/Ukraine Season of Culture devised jointly by the British Council and the Ukrainian Institute.
(Re)Grounding.
D6: Culture in Transit, Newcastle
2022-23
(Re)Grounding is a new programme that explores the climate emergency in post-industrial contexts through two research residencies connecting artistic practice, heritage and communities in the UK and Ukraine.
We know the climate crisis spans social, political and environmental injustices that must be addressed to achieve a sustainable future. We are seeing these injustices play out in Russia’s invasion of Ukraine, which is deeply affecting the people and places and destabilising global food and energy markets. We can see the climate crisis impacting people with the least resources to tackle it. We can also look back to the global impact of the industrial revolution on the climate crisis today.
The selected artists Alexandra Clod and Karolina Uskakovych take these interconnections, asking what must be done to bring about the drastic change needed to limit the increase in rising temperatures. The programme includes two research residencies and an exhibition connecting practice, heritage and communities between the UK and Ukraine.
Book of the dead. Alexander Krolikowski.
GIsela gallery. Berlin
2022
Documentary photo, project idea Alexander Krolikowski (UA)
Sound: Mykyta Gavrylenko (UA), Mykola Shostov (UA)
Video Artist Talk, shooting and editing: Paul Shpil (UA)
Curating: Lucy Nychai (UA)
Co-Curating: Dmytro Goncharenko (UA/DE)
The “Book of the Dead” is a cultural documentary artefact, a rethinking of the artistic experience. It is possible that in the future, this artefact will become anthropological material for studying the confrontation of ideologies at the expense of civilians of Ukraine. The aim of the project is to translate the experience of a morgue volunteer into a holistic statement in the language of art – to make the horrible occurrences real on an emotional level, to provoke reflections outside of geopolitics and propaganda. The creator of the project is the artist Alexander Krolikowski, who worked for three and a half weeks after the liberation of Kyiv as a volunteer in the morgue of Vyshgorod, where the tortured bodies of innocent victims of Russian aggression were taken care of.
According to the latest estimates, 1290 residents of the Kyiv region were deliberately killed by the Russian occupiers.
From the author: "The Book of the Dead" is a synthesis of instant photography during volunteer work with the bodies of the dead civilians of Bucha, poetic instant photography, and my own memories of meeting death. "Book of the Dead" is a metamodern iconography of one of the most important events in human’s life -Death, through the prism of the Russian-Ukrainian war. Death is an event that created or destroyed meaning for all previous generations of people. And each generation of artists created a portrait of their era, describing the attitude toward death. The memory of the dead is not needed by the dead themselves, we, the living, need it to draw conclusions and learn to value our own lives and the lives of others.”
By support of Goethe Institute and GISELA - Freier Kunstraum Lichtenberg
Collective Ukraine. Exhibition of CryptoArt Ukraine. (Co-curation)
Side ivent. WEB Summit, Lisbon
2022
Collective Ukraine is a unique NFT collection from Ukrainian crypto artists on the NEAR blockchain. Featuring well-known artists in cryptoart scene and perspective newcomers with impressive stories in the traditional art world.
Internal Elements.
NVAIR, Ukraine
2022
The project began as an experimental digital art program. Together we studied and mastered new opportunities for implementation. Learned to create NFT collections and virtual galleries. We created Twitter accounts and got acquainted with the CryptoArt Ukraine community. We have internally displaced persons and residents of the NVAIR emergency program, who are going through war together in an art residence in Ukraine. Several months ago we met again to create a new world together, a new shelter, and at the same time a new project.
The reaction to premonitions, fear, and any changes are different, but we create art in any situation. It unites us and gives us the strength to live life in difficulties. We have become a little different and ready to talk about it.
“Now I live in the same shelter with artists and IDPs in Western Ukraine. Everyone had a history before the war, but now we are living a new life together with our families.
The whole world around becomes more cruel, fragile, and uncertain. But we decided to resist hatred and destruction, support others and share kindness. It is psychologically difficult for everyone to realize that dear people are in danger, but we hold on, “like a locker, a dog and a cat.” We will share what we are strong in. Intuition, love, healing, and consequent self-confidence, trust, and unity.”
Lucy Nychai, program curator and artist
The project currently has 4 authors and 4 series of digital works. While the war continues, the collection will be replenished with new authors and works.Artists:
Lucy Nychai
Olexandra Pavlovska
Karina Sofit
PaulShpil
Artist is Absent in 2022. Global cohort.
Online
ARTIST IS ABSENT - This is an international program of virtual residencies for digital artists.
It takes place in cooperation between art residences NVAIR (Ukraine), Schafhof (Germany), @KAIR (Slovakia)
Initiated by the NGO @Congress of Cultural Activists within the framework of the @Nazar Voitovich Art Residence (NVAIR)
Team of mentors:
Lucy Nychai - Curator of international exchange programs of art residence for youth artists NVAIR, Curator-at-Large Lite-Haus Gallery (Berlin), communication and curating of program
Vartan Markarian - Digital artist (XR), Art director of the international project “A:PART Berlin-Poltava”, tech-curating of programThe AIA program is the birthplace of new ideas and meanings for international dialogue through art. We focus on common issues and topics for dialogues about the digital art ecosystem. The name of the program reminds us of new algorithms and technical capabilities of tools for creating art. In the program, we look for the importance of the artist as a carrier of ideas and the weight of tools that bring new meaning to the process.Artists:
Sofia Talanti (Italy, Florence)
Chia Hsien Lin (Philadelphia /United States)
Manana Kobakhidze (Tbilisi, Georgia/ Germany)
Renata Pinterova (Štúrovo, Slovakia)
Oksana Kryzhanivska (Zhuhai, Guangdong, China)
Vitaly Yankovy (Ukraine,Vinnycia)
Eric Millikin (Richmond, Virginia, United States)
Florian Lechner (Munich, Germany)
Sarawut Chutiwongpeti (Bangkok, Thailand)
Melissa Hernández & Byron Blanco (Guatemala City, Guatemala)
Merlin Stadler (Munich, Germany)
Transformation 2021. NFT exhibition of CryptoArt Ukraine. (Co-Curation).
Blokchaine Conference, Kyiv, Ukraine
2021
"Regarding art's potential to enchant, it is important to ask whether art and the artist need to be at the forefront of technological development to play a role in shaping the digital society"
Jefferies, Janis. 2016. “The Artist as Researcher in a Computer-Mediated Culture.”
Transforming into crypto-art, senses have the opportunity to exist at new levels and be full participants in changes.
The transformation continues not only in tools and algorithms but in communication between artists, collectors, and institutions. The emergence of new ways of interaction thanks to crypto-art changes the art market and expands opportunities for each participant in the processes.
CryptoArt Ukraine uses blockchain technology to talk about reality and fill the digital world of art with meanings and discussions, new ways of interaction, and communication in a global context.The mission of CryptoArt Ukraine:
1. To help Ukrainian creative people to develop using crypto ecosystems
2. To develop the image of the Ukrainian crypto art scene globally as a friendly, diverse, cohesive, open, and progressive scene with representatives in various genres and ecosystemsAt the exhibition, the community is represented by a small group of individual artists, whose works in one way or another speak about the processes of transformation that we are all experiencing here and now.
Changes and flows, transformations and renewals are precisely the kind of narratives robots talk about. Behind each digital matrix of pixels is a whole story of a person who changes along with the world. Each author is an experienced artist with years of artistic practice behind him, some of the artists worked in analog media even before the hype around new possibilities began, some have been creating digital art for many years, and for some artists, the appearance of NFT became a real discovery for self-realization and transition from design and film industry to independent art.There has never been such a large and friendly circle of creative people who would so independently and at the same time jointly transform the very concept of the art scene in Ukraine and sincerely communicate with each other. This new world happened because people were already ready for it, we were transformed, and the decentralized economy gave us the opportunity to show ourselves.
Open Studios. AIR program.
NVAIR, Ukraine
2021
Open studios are a residency format that allows us, firstly, to experiment, secondly, to implement our own projects without any limits, and thirdly, to get to know each other online and offline and to collaborate.
Each selected artist gets his own space to realize his idea, as well as the opportunity to receive feedback on his projects. Usually, a new space prompts new practices, so experimentation is a key opportunity we offer. It's about the place.
In the "Open Studios" program, we are open to absolutely various mediums and topics of research, we choose those applications from artists who understand the importance of implementing projects in Travneve Village and in this format. It's about context.
And the final and most important opportunity, as for any program of group residences, is communication and collaboration, and hence the opportunity to receive support and expand one's own experience. And this is about people.
This program is a pilot and we are also experimenting.
This year, the program is supervised by Lucy Nychai in collaboration with mentors from Krolikowski Art Duo. We have time to jointly find the best in our idea, to explore the reflections of the participants in order to introduce a new format for the Nazar Voytovych Art Residence on a permanent basis.
The program takes place with the support of the local community as part of the activities of the Branch of the Zbarazh Center for Culture and LeisureParticipants:
Krolikowski Art Duo (Vyshhorod)
Leland Beaty (Ternopil)
Karina Sofit (Kyiv)
Yaryna Datsko (Lviv)
Yuriy Ivantsyk (Lviv)
Darya Molokoedova (Kramatorsk/Kharkiv)
Nina Marie (Kyiv)
Zirka Savka (Lviv)
Roman Khrushch (Lviv)
Katya Kostelna (Lviv)
Lost in Time. Bohdan Svyrydov. Personal exhibition.
All-Ukrainian Youth Center. Kyiv
2020
Lost in Time is about objects and people who have lost their past and cannot get into the future
Painting/photo/video/discussionThe personal project was prepared for six months and was expected to be presented in March in Kyiv and in May in Berlin, but the pandemic made its adjustments, and not surprisingly, it became even more relevant in the global lockdown. During the exhibition, we discuss artistic reactions to the crisis in the framework of the international project “Transit Dialogue”, touching on the fall of the Berlin Wall and the Iron Curtain and the transit generation of countries with a common past.
Artist is Absent. International virtual art residence.
MozillaHubs platform
2020
Artist is absent - collaboration of artists with artificial intelligence and virtual reality.The creative processes began with a game of co-authorship involving a random selection program to move from complete control of the authors to the intervention of artificial intelligence, which already questioned authorship and rather provoked the collective creative consciousness. Perhaps this is closest to imitating the processes of collaboration that occur in physical programs with the close interaction of artists.
In the process, it was determined that the main idea for working within the project should be to find and study the processes of creation, which can interfere with outside activity and reflection on these processes. Each artist had their own, and quite different, themes with which they worked before. These are the interaction of material and form, the transformation of the visual and the impact of time, conflicts and environmental disasters, practices with digital tools and interest in artificial intelligence. All this, intersecting in the process, turned into a project space in Mozilla Hubs. The central hall was designed by Vartan Markaryan according to the curator's plan in cooperation with all participants of the program. This is a virtual model of our real program. In the middle of 4 empty chairs is an image from the real central workshop of the Residence. An additional advantage in the virtual space is the difficult mobility, only regular users can feel comfortable there. There are 4 corridors in the central gallery, which lead to isolated halls with projects of individual artists. In general, the room is a virtual image of the real situation in quarantine as a whole.
NVAIR 2020 - International online exchange program for art residencies. The program was founded by the NGO Congress of Cultural Activists on the basis of the Nazari Voitovich Art Residence, which has been working since 2017 and is physically located in the Ternopil region. The aim of the program is to support young artists through international residency projects and artist exchanges with partner organizations in Germany and Slovakia.
This year, due to the pandemic, physical programs were postponed to next year, but in collaboration with Schafhof - European Center for Art Upper Bavaria, we decided to try the online format and got a successful collaboration of Ukrainian and German artists.
Artists:
Johnny Linder (Munich),
Bogdan Svyrydov (Cherkasy),
Constanze Budcke (Munich),
Vartan Markarian (Poltava)Program curator Lucy Nychai
The presentation was made possible by the institutional support of the UCF
Two dots. Virtual group exhibition of Ukrainian Artists.
Kunstmatrix platform. NV Gallery
2 – 28 June 2020
This exhibition aims at visualizing the interval of time – emotional spot on our mutual history. TWO DOTS – which calls for itemizing the genitive cases, TWO DOTS above "Ї" – which is the marker of our identity, TWO DOTS, which requires continuation and interpretation.
Who are we? How are we? What do we feel? What’s bothering us? How do we act? What do we want?
The narrative: not so long ago we were seeing the Maidan in flames and the execution of the murderous orders by the authorities, but even in those times we were closer to democracy. We are in the process of the war with a guileful neighbor, which destabilizes our country and again dunks us in the totalitarian past. We are horrified by the isolation, by the lots of restrictions, by the pressure upon our responsibility, and by fulfilling the dictatorial ambitions behind our backs. The transit generation perceives this as the flashback from childhood, before the collapse of the Soviet Union and the Iron Curtain. This generation reaps the consequences the totalitarianism, doctored to death. Stalino and Voroshylovgrad on the Victory Day in 2020. We are the country with temporarily undetermined borders. The generation, who was growing up in the process of war, has already appeared in Ukraine.
On our own, in the so-called “self-isolation”, reading the tons of literature, which was waiting on the shelves, listening to the tons of lectures, webinars, and courses, we may feel a slight discomfort without the live exchange of thoughts, ideas, and emotions, without the possibility to get on the train and get up in any part of the country, which we have only started to explore recently. We became accustomed to having the right to peaceful assembly, we have even got used to the fact that the majority of borders are conditional for us. And the generation has appeared, which do not feel what the borders are.Curator - Lucy Nychai
Curator Assistant - Olena Kainska
Pawns. Olexandra Pavlovska.
Odessa photo week, Ukraine
2018
PAWNS
This is a collection of photographs of the village of Travneve and its inhabitants. Due to historical circumstances, the deportation of Ukrainians and Poles in 1945-46 was suppressed and virtually forgotten. Forcibly displaced peoples – that is the story of the entire village. The present-time inhabitants of Travneve comprise those directly affected by that vile act and their descendants, although the latter ones are very reluctant to share their memories for fear they might take hold of them again.With this project, we want to draw public attention to the importance of historical memory and truth, which can overcome conflicts and become a basis for mutual understanding among the descendants of their difficult history, so that it does not happen again. Because of oblivion and suppression, we already have a fresh conflict in the East of this country ...
Values on the way. Group project.
Lite-Haus Gallery. Berlin, Germany
2018
The residency was organized by the NGO Congress of Cultural Activists and the NGO Youth Development Center Bridge. The exhibition is organized through the support of public funding from the Ukrainian Cultural Foundation.Within the framework of the program, the artists re-thinked communication mechanisms in society, investigated the visual and verbal flow of information, destroyed their own stereotypes and set up communications in search of impressions. A special inspiration was the place, residency village characterized by calmness and magnificent landscapes, filled with life. Artists spent four weeks in September under the exchange program with the Košice Artist in Residence (K.A.I.R.) in Travneve, Ukraine.
The creators included in this exhibition are Oleksandra Pavlovska, Denisa Slavkovska, Eduard Klena, Sergio Kovalov, Karina Sofit, Larisa Fedorenko, Alyona Kuznetsova, Valeria Tarasenko, Anastasiia Kostenko, Stanislav Tolkachov, Vitaliy Agapeyev, and creative couple Julia and Pavlo Spylovyi.
NVAIR - International exchange program of AIR Ukraine-Slovakia-Germany.
NVAIR, Ukraine
since 2018
The International Program of Artistic Residency Programs for Young Artists is a project based on the Nazarii Voytovych Art Residency (NVAIR), designed to develop a network of international partnership institutions to develop opportunities for Ukrainian young artists to gain work experience in international projects and to form a positive image of Ukrainian art and Ukraine as a whole abroad. It is carried out in partnership with KAIR (Koshice) and SCHAFHOF (Freizing, Munich).
The art residence named after Nazarii Voytovych, which was founded by the Congress of Cultural Activists, the NGO "Congress of Cultural Activists" and the NGO "Family of Heroes of the Heavenly Hundred" in 2017 in honor of the youngest Hero, in cooperation with international organizations in 2019 launched exchange programs for young artists thanks to the support of the Ukrainian Cultural Fund to the NORD program: Training, exchanges, residencies, debuts - the UKF program.
Nazar Voitovich Art Residence
since 2017 - ongoing
Mission
The aim of the project is to pay honour to the youngest Heavenly Hundred Hero via forming an important institution for the local community development and the development of an artistic view of the Ukrainian youth that will be a unique lifelong project in Ukraine.The project is a component of a big idea of Heroes awards that is to pay the honour and make a possibility to continue cooping with the started deals of the Heavenly Hundred Heroes and realize their dreams that they had before the key days of the Revolution of Dignity. Thanks to the project “Nazar Voitovich Art Residence” which will be organized in the home village of the youngest Hero of the Heavenly Hundred, we will have a chance to award the community which has brought the bravest and kindest hearts of the talented artists, whose life was stopped when he was 17 years old.Vision
The Art Residence is a free cultural space where educational and cultural projects will be realised during the whole year. Annually according to the results of the international art competition, the young artists get a chance to realize their projects in cooperation with coordinators and to present their works in both Ukrainian and foreign countries' institutions.The work priorities of the Art Residence are:
the local community development;
implementation of the innovative, ecological, economic techonologies via culture into life
education via practice and communication;
the development of the idea and person mobility;
support of the professional career of the young talented Ukrainian artists and form relationship with global art market.
Lessons of Dr.Tulp
Onnes. Film producer
(2012)
Film about the unity of man and creative force of nature, its loss and finding, to be reborn through the pain. The perfection of nature, the beauty of the body and music ...Performed by Ernest Palchikov
Directed by Pavel Shpilyovyi
The original idea by Ludmyla/ Lucy/ Nychai
Director of photography Gregory Rudenko
Music by MOBY
Editing by Pavel Shpilyovyi
Visual effects Pavel Shpilyovyi & Gregory Rudenko
Producted by Lessons of Dr. Tulp studio
Text
Fractality of chaos.
Visual program of the Gogol Fest. Kyiv, Ukraine
2012
Text
Factory project.
Gallery for youth artists. Art spase 365, Kyiv, Ukraine
2011
An open, public photo-video studio. A place for experimental cinema and artistic photography
Art space 365. Gallery for youth artists.
Kyiv, Ukraine
(2010-2012)
A gallery for the first personal exhibitions of young artists. A place for collaborations of representatives of various mediums.
During its lifetime, the gallery implemented 21 exhibition projects, a number of lectures and master classes. It became a meeting place for the creative youth of Kyiv, when public non-commercial art and socially responsible business were not yet fashionable in the capital.The gallery is an initiative of 4 friends - founders of Design 365 studios (Taras Donenko, Oleksandra Pavlovska, Oleksandr Belyaev) and art critic Lucy Nychay
ARTISTIC PRACTICE
I would be happy to sit in my studio, rewriting the shapes and lines I observe in nature for inspiration and to encourage others to fall in love with their surroundings. But… I live in a turbulent time, acutely aware of environmental, political, and social injustices. My country has been at war for 10 years; my identity remains invisible and often blamed, and my environment is exhausted. My skin is too thin, my perception too sensitive, to remain silent. I cry out about pain, voice my worries aloud, and argue for everyone's responsibility in everything.
My strength lies in anthropological analysis, the reflection of knowledge, and practical action. I can’t sit idly in my studio wasting materials—I want to make/be changes. My starting point is always to generate questions and share personal stories.
My birds cry out stories; my leaves call for a new attitude towards memory; my embroidery reveals the unseen; and my videos shed light on truths.
I carefully choose the medium for each artwork. I work with traditional embroidery and digital sound, participatory actions and solitary practices. I imagine my projects in dialogue with the perception of the audience. I enjoy creating spaces and atmospheres that allow viewers to immerse themselves in the themes I explore.Two of my favourite books were on my dad's bookshelf: "Encyclopedia of Animals" and "Anti-Art" (the Soviet version of art criticism in the beginning and middle of the 20th century). These books influenced my worldview to appreciate the vastness and diversity of the world. I personally feel that there is something amiss and artificial in society, and I spend my life searching for ways to fix it. I have a youthful mission, and my artistic practices serve as both magic spells and self-therapy. They emerge when I am unable to endure or remain silent. When I am unable to fix things in reality, I channel it into my art.
I eschew hyperbole and hypocrisy in art and instead rely on direct comparisons and analogies to connect with a diverse audience. My artwork strives to initiate conversations with an ordinary person, avoiding mere philosophical debates. My style is a fusion of pop art and post-graduate symptomatic expression. Whenever I witness injustice, I am compelled to express myself through various mediums such as easel and monumental graphics, digital art, sculpture, and interventions. I like to put in surrounding artificial forms and showcase the creative process. To captivate indifferent audiences, I employ "quiet interventions" that blend into their surroundings, gradually revealing themselves over time in communities. This technique is particularly suited to my murals, sculptures for festivals, and site-specific projects. My most ambitious and daring endeavour yet is the "Nazar Voitovich Art Residence" project. The NVAIR project has undergone an evolution from a mere art project and object to a dynamic subject that adapts to and influences external circumstances. It has now achieved local positive meme status, become a part of everyday language, and is a widely recognized location.
Public presentations
| Title | mediums | Year | exposition |
|---|---|---|---|
| Good Intentions Project. | Graphic novel, animation | 2025-2026 | Good Intentions: sharing and discussion with Lucy Nychai. D6:Culture in Transit, Newcastle upon Tyne, UK |
| Black Sheep Project// "Who am I?" and "Personal pattern" | Embroidery and story, hemp canvas, synthetic wool | 2025-2026 | 2026 Group show "Growing through the cracks" at Koyodai, Inagi City, Tokyo, Japan./ 2025 "Unresolved Landscapes" Marginal Art Fair, Fukushima Hirono, Japan./ 2025 Group show "Growing through the cracks" - Ukrainian exhibition at the Tokyo Catholic University, Japan. |
| Roots in the Glass of Water | Video, Sound. Duration 4:48 | 2025 | Nowhere/ Now Here. The outdoor performance and exhibition by the Ukraine-Tynedale artists' collective. Burnlaw, Hexham, UK |
| My refugee lyrics | Table textile, linocut, stitching | 2025 | The group show “Community as a Superpower” for Refugee Week 2025. Newcastle University XL Gallery, Fine Art Building, Newcastle, UK |
| Series “Monuments” | Canvases, ink, acrylic, liquid metal | 2025, 13th June - 2nd July | The group show “Community as a Superpower” for Refugee Week 2025. Newcastle University XL Gallery, Fine Art Building. Newcastle, UK |
| Black Sheep Project// "Who am I?", "Mourning" | Embroidery and story, hemp canvas, synthetic wool | June 2024 | Lost and Found - group exhibition Ukraine/Tynedale Collaboration, Queen's Hall Gallery, Hexham, UK |
| Resettlement. Berlin. 2024 | Research, site-specific collaborative art practice, and ink on paper | Jan-Feb 2024 | Resettlement - personal project, pop-up group art residence, Exhibition "Autonomy+Dignity", Lite-Haus Gallery, Berlin, Germany |
| System of Defence | Installation.Leaves, plastic shields, epoxy resin, “PictureThis” digital application, Photos | 2022-2023 | NOMAD, Group exhibition into Black Sea Festival, Timisoara, Romania, June-July 2023 |
| System of defence. | Installation.Leaves, plastic shields, epoxy resin, “PictureThis” digital application, Photos | 2022-2023 | D6:Culture in Transit, The Late Shows, Newcastle, 2023 |
| The Cry of The Nightingale | Ink painting, storytelling | 2021- 2022 | OrrGallery, 70 Auchmithie, Arbroath, Angus, Scotland, 2023 |
| Intuition. Part of the collection “Internal Elements” | Audio-visual compositions | 2022 | Global VR exhibition on oncyber.io/spaces |
| Oda of Memory | wall drawing | 2020 | Culture Club 'Suputnyk', Parajanov Fest, Levandivka, Lviv, Ukraine |
| Svarga. The unstopped heart | wall drawing | 2018 | NVAIR, HandPrinting Studio, Ukraine |
| Not every bird across the Sea. | video, plaster sculptures | 2014 | Ford Otosan Art Gallery, Gölcük, Kocaeli, Turkey |
| Pieta for Democracy. | batik | 2014 | The Seimas of the Republic of Lithuania, Vilnius, 2016 |
| My in Arc. Personal show | oil painting | 2012 | ArtSpace 365, Kyiv, Ukraine |
Good Intentions Project
Graphic novel, animation, storytelling
2025-2026
Presented in the Earth Day, 21st April, at D6:Culture in Transit, Newcastle, 2026
The Good Intentions Project - was developed as part of Lucy’s participation in the Climate Adaptation for Creatives Course. It is an experimental artwork shaped through peer exchange and mentorship during the programme. The project is supported and funded by Black Mountains College and the British Council.GOOD INTENTIONS
Graphic Novel by Lucy Nychai
The novel is a compelling philosophical journey that addresses the urgent crisis on Earth, spurred by human intentions. Through vivid illustrations and profound narrative, it aims to provoke thought, elicit smiles, and spark meaningful discussions about our collective impact on the planet.GOOD INTENTIONS (GI) Production
The GI graphic novel has been animated to enhance accessibility and now GI offers a more affordable way to experience the story!
The author of this novel is the Ukrainian artist and curator Lucy Nychai. The artist created the original plot and produced the soundtracks and pictures.
The voice was provided by Y.Stets.
The animation was created by PaulShpil.
All rights have been secured for publication!The recent animated graphic novel, Good Intentions, takes the form of a fable - a genre traditionally written for children - but reimagined for adults. Through vivid illustration and storytelling, the work offers a philosophical take on the environmental crisis and the consequences of human intention. It is thoughtful, unsettling, and humorous at times, inviting reflection on our collective impact on the planet.
Screening and Discussion
The Good Intentions animation opens the door to explore how - and how best - we speak about and visualise the climate crisis.
Roots in the Glass of Water
Video, Sound
Duration 4:48, 2025
Presented on 21st September during "Nowhere, now here" performance day with Ukrainian-Tynedale Art group,
Seeds of Hope, 2nd edition
Burnlaw, Hexham, 2025
This artwork explores the process of willow rooting as a celebration of the vitality of nature. The concept emerged from personal reflections on enforced migration due to war and the experience of living in a peaceful, fertile environment. In these remarkable conditions, surrounded by like-minded individuals, I have been able to maintain my professional trajectory while developing new social connections and engaging with the local cultural movement. I felt a readiness to settle here, having established my emotional roots. However, due to my social status, I have come to realise that there is no solid ground for me.
I have been practising the tongue pan for calmness. The recording of a night-time tongue pan meditation serves as the backdrop for the video-captured process of expressing wishes. The voice from the radio was occasionally captured during breakfast, the calmest time of day, while I engaged in birdwatching.
Video - Lucy Nychai
Sound - Lucy Nychai
Voice - Radio ether (occasionally captured)
Editing - Paul Shpil
My refugee lyrics
Table textile, linocut, stitching
2025
Presented on the group show “Community as a Superpower” for Refugee Week 2025, 13th June -2nd July.
Newcastle University XL Gallery, Fine Art Building (King Edward VII Building)

Thus began my journey, adhering to a light regime out of habit, silence due to my poor English. Avoiding conversations with strangers because of the meme about “kill joy” and discussions on the benefits for Ukrainian refugees. And then comes the relief when the community no longer pities you, accepts you with your weaknesses and strengths, when you realise that you are in your peaceful creative bubble.
In the form of a clumsy free verse created by me in collaboration with AI, it reads upon exquisite table linen from Cyprus, capturing what exists between the lines of the stories of forced migrants.You step onto unfamiliar ground.
Your steps are deliberate, attempting silence.
You face fresh challenges, adding to your confusion.
Only gestures of acceptance offer a sense of peace.
In the end, your steps start to leave footprints.
Black Sheep Project, since 2023 - ongoing
A part of Project. The compositions "Who am I?" and "Mourning"
Embroidery and story, hemp canvas, synthetic wool
Lost and Found - group exhibition Ukraine/Tynedale Collaboration, Queen's Hall Gallery, Hexham, UK,
June 2024

Lucy Nychai - The series “Resettlement. Berlin. 2024”
Resettlement - the pop-up residence and exhibition
Lite-Haus Gallery, Berlin, Germany
January-February 2024
Lucy Nychai - The series “Resettlement. Berlin. 2024”
I’m a curator and multidisciplinary artist. Before the war, I lived in Kyiv.
I worked with an artist-in-residence program in the west of Ukraine and with community research in the east of Ukraine. Since 2022, I have lived and worked between the UK and Ukraine, and sometimes I visit Berlin.
I work with the topics of memory and commemoration, sustainable ecosystems, and site-specific projects, and study ethical issues of digital art. Over the last 10 years, my art practice has focused on the impact of the Russian invasion of Ukraine. In my art practice, I use different mediums like video, mural, sculpting, drawing, Indian Ink and embroidery.
Over the past three years, I've channelled my emotions through the uncontrolled flow of ink on paper. This practice has become my way of training myself to maintain clarity of mind in diverse circumstances—to learn to accept life and death around me without placing blame on myself, especially amidst the challenges posed by COVID-19 and war.
When I arrived in Berlin in January 2024, I immersed myself in studying my surroundings. Initially, I explored Neukölln, Kronsberg, and Tempelhof alone. As I delved deeper, I began discussing my discoveries, such as Treptower and Görlitzer, with others. Along the way, I encountered the juxtaposition of nature's beauty and societal complexities. Rather than attempting to change a world that isn't mine to alter, I returned to honing my skills in Indian ink.
My improvised coloured forms are supplemented with chaotic mycelium, which symbolises mutual influences and relationships in society and also maintains a certain level of humidity.The series, 2024:
“Autonomy” A5, Ink on paper
“Sacrifice” A5, Ink on paper
“Absorption” A5, Ink on paper
“Feud” A5, Ink on paperResettlement is a pop-up art residency programme designed to rethink the conditions and challenges faced by migrants in their journeys. This long-term project took place at Lite-Haus Gallery + Projectarium, where I became the curator of one of the rooms, organising group practice and the final exhibition with six local and resettled artists.
We worked with a specific set of materials and tools to create new artworks. During the sessions, we discussed each participant’s experience in this shared laboratory. Altogether, we held five creative sessions with the artists and organised two public events during the course of the exhibition.
Each session centred around a different theme—home, travel, neighbourhood, autonomy, and dignity—which we explored through conversation and collaborative practice. The gallery rooms became a cooperative studio space for myself and six Berlin-based artists: four Ukrainians and two artists originally from Turkey and Iran.At the exhibition titled “Autonomy and Dignity”, we presented the artists’ works alongside their personal reflections on the process. In addition, we co-authored a Common Statement on dignity and autonomy. During the public events, we invited the audience to contribute their own thoughts to this collective statement, creating a shared space of dialogue and expression.
System of Defence
Installation.
Leaves, plastic shields, epoxy resin, “PictureThis” digital application,
Photos (Author Svitlana Pohasiy)
2022-2023
2023 - ‘Nomad’, Group exhibition for Timisoara Culture Capital program, Black Sea Art Festival, Timisoara, Romania.
2023 - Late Show, D6:Culture for Transit, Newcastle, UK
The protection system of trees is very well thought out. When the seasons change, strong winds occur in nature. The warm and cold air masses cause hurricanes and storms. The memory of the trees is unfailingly triggered every autumn, they drop their leaves so the heavy crown does not uproot the tree. Trees shed their leaves so that the tree can survive.We also react to the approach of winter and as we look at the colourful autumn leaves we start to feel melancholy and sadness. People most often have depression in the autumn. In my work, I compare natural mechanisms with war. A country is like a tree, which has a military protection system. We lose people to save the country - a tree and its roots. We mourn and #standwithUkraineI feel despair, I can't do anything, my people are dying every day.I collect memory in different ways. Last autumn, I collected fallen leaves in various cities in the northern hemisphere. In childhood, leaves were given values, they were money, toy food, and clothes for flower dolls. They performed magical tasks and hid us from imaginary dangers. Collecting the leaves, as an adult, felt a little strange, mad and silly. But in this way, I mourned with my people those who died in the cursed war; Those who gave and give their lives every day for the survival of the whole nation.In November I brought leaves back in homemade wax paper bags from Boston. As I started
to recognize each leaf, I felt goosebumps. I was working like an expert in the Hague laboratory... that month, they started work on the #Olenivka victims.In my description, I don’t use the number of victims. Whilst less sensationalist, I wanted to highlight the narrative that each fallen person brings a whole sea of tears. This war is significantly personal.
The project is dedicated to fallen soldiers.
Under the impression of the
Peter Wohlleben book "The Hidden Life of Trees"
The Cry of The Nightingale
Ink painting, storytelling
2021- 2022
exhibited at OrrGallery, 70 Auchmithie, Arbroath, Angus, Scotland, 2023
“When everyone started talking about a possible attack by Russia without leaving the state of quarantine, I pushed this thought away, because it has been attacking for 8 years already - the truth is silent.
Friends began to hint that I should be ready for war. But I had no idea what it meant. Yes, we had instructions on how to prepare for evacuation, well, that's all. I wasn't going to run away, so this month I just drew my worries on paper. This is how my 4 birds appeared, whose cry warned of danger. Foreboding, contrary to disbelief, of the attack poured into the works. The last burning bird was like a vision - I really don't like it when this happens to my consciousness, but I created it. This is one of the most difficult jobs - which later became a symbol of Mariupol under siege, when I replaced the cry of a bird with the screeching of metal.That day, about 2 weeks before the invasion, an old friend of mine - a former German soldier - wrote to me. He asked how I was doing. I complained that it worried me. He reassured and said that neither Putin nor Europe wants war, so nothing will happen, don't worry. But he advised to pack an emergency suitcase with documents, water and dry food.
Maybe this is what prompted me to prepare for evacuation...”
Intuition
Audio-visual compositions.
The works are beginning to appear in anticipation of war. Disturbing visions in the form of frightened birds - inhabitants of different parts of the world - a continuation of the project "Fluidity", started as self-therapy during the pandemic.Part of the group's collection “Internal Elements”. 2022, Ukraine
Intuition. Seagull anxiety
Seagulls are considered a synanthropic species - they live near humans and benefit from it. The alarming cry of seagulls announces the approach of the storm, and people benefit from it too. My premonitions were lingering and muffled as if a flock of seagulls had settled inside me.
Analogue graphics/ Video motion/ Sound/ mp4/ 40,4 MB
Feb-March 2022
Intuition. Penguin of York Bay
These birds live in a minefield, but their ecosystem is more threatened by human activities. Demining can destroy their environment, only human intervention disturbs the penguins and they cry anxiously to protect their nest. Paradoxically, they owe a wonderful ecosystem to one of the most terrible human catastrophes - war.
Analog graphics/ Video motion/ Sound/ mp4/ 45,8 MB
Feb-March 2022
Not every bird crosses the Sea.
video, plaster sculptures. 2014,
Ford Otosan Art Gallery, Gölcük, Kocaeli, Turkey.
The project was created in the 3-week art residence program in Helicon Art Centre after
the occupation of Crimea.
Not every bird fly across the Sea project is a street installation, a broadcast of interviews with former prisoners of Crimea, and a performance during the entire residence. Installation: 5 plaster birds with pieces of hair in their beaks, some are midair, the others are in the process of landing on their feet and one is killed by the surface.
The project aims to remind you that not all news reaches the international community. Much of it perishes along with the bodies of its messengers, much is shared solely within colleagues or communities, and the majority of what does reach the world is grotesquely distorted.The “Not Every Piece of News Can Reach Over the Sea” or "Not Every Bird Crosses the Sea" project is a street installation featuring interviews with former prisoners from Crimea.
Installation: five plaster birds with strands of hair in their beaks—some mid-flight, others in the process of landing, and one that did not survive.Amidst the barrage of information and disinformation, the truth has been obscured, a reality that has persisted for the past six months—one that can only be recognised by those willing to trust their own eyes.“Individuals wielding cameras and phones, adorned in the colours of yellow and blue or red and black, are the most perilous, the most unpredictable, and the most extraordinary. They work without payment and abstain from drugs, yet they fearless rush into hazardous zones to rescue others.” This is the stark truth, yet it undermines the military’s perception of order. During arrests, abductions, and interrogations of these remarkable individuals, those armed—commonly referred to as “green men”—have resorted to appalling forms of torture against the captives. Boys have had their trousers removed, while girls have had their hair severed with knives, all amidst threats of violence and various grotesque amusements that defy life itself.Humiliation is weaponised against these proud revolutionaries. Abduction itself is an act of humiliation, performed in front of a stunned audience. We stood on the Maidan in the biting cold, realising that no law could resolve our plight. In Moscow, laws hold little significance. As a Russian saying goes, “fools are fools—they abide by no rules.” Yet, it is we who have been made fools. All who believe in a civilised world have been humiliated on every conceivable personal level.A friend of mine was held captive in Crimea for two days. On the first day, her captors—those so-called “green men” from Don—cut a clump of hair from the crown of her head.
Pieta for Democracy
batik, created in 2014
The Seimas of the Republic of Lithuania, Vilnius, 2016

During the Revolution of Dignity from November 1, 2013 to February 20, 2014, the time between being at the square, sorting products, organizing meetings and art actions, I meditated with the batik technique. The technique is very painstaking and requires concentration, so it kept me on my toes every day until I got on the last subway, and sometimes calmed me down when my excited brain couldn't fall asleep.
This work was born for about two weeks in February 2014. My magic was - to complete the work - the conflict will end - the old government will disappear. Everything almost happened like that, everything ended in one terrible morning, when I fell asleep very soundly for the first time in a month. A day before, my friend and I were carrying food and water to the Maidan, because most of the supplies were burned in the building of the Trade Union together with people who could not get out of the flames. And that morning, when I was sleeping sweetly, more than 60 people with wooden shields and plastic helmets were killed by the police and special forces on the Maidan.
The depicted scene is similar to the canonical biblical stories, but it is a real story of the family of my colleague from the University and her son - a graffiti artist. He was mercilessly beaten near the president's office, but fortunately he survived.
When the work arrived in Vilnius, the ambassador saw his monument to the Revolution of the 90s. The work now symbolizes the struggle of the two neighboring nations.
Other project
My in Arc
Personal show
oil painting
2012
ArtSpace 365, Kyiv, Ukraine
My in Ark - redefined symbol Noah's Ark in Ukrainian (Мої'в Ковчег) sounds like my (friends) in the ark!
My ark is 23 paintings - portraits in the style of mystical realism, abstractly summarizing the meaning of dreams and reality.
The project is the result of rethinking oneself and the world during life, through thousands of reincarnations in dreams and in reality. The impetus for the final realization was the same dreams. Now my nightmares are about the End of the World and salvation in higher forms of energy - spirituality. "My portraits show people who share my space. They came to the Ark themselves, and while they are here, I do not worry about the future of the world."
canvas, oil, size: 120X120, 120X150, 110X150
Svarga. The unstopped heart
wall drawing
2018
NVAIR, HandPrinting Studio, Ukraine
created in honor of Nazar Voitovich
Oda of Memory
wall drawing
2020
Culture Club 'Suputnyk', Parajanov Fest, Levandivka, Lviv, Ukraine
Post-quarantine reality
"But I'm lost in time" /
Ode to memories, dreams and hopes"
An airplane that hangs in the air for an indefinite period of time signals an indefinite location in the material world. Only celestial triggers provide clues to the involvement of a planet on which life abounds. Trigver or trinig symbolized, according to some, the sky, earth and air, according to others - air, fire and water, still others considered it a symbol of human life. The fourth interpreted it as a symbol of heaven, earth and hell. (from wikipedia) Whoever turns out to be True in his guesses, it does not matter, because we are talking about eternal movement and life.
As in any time of terrible pandemics, people had only to believe and live in a relative reality, where faith and amulets - symbols that filled their lives - gave even a ghostly hope of salvation. We are like that plane stuck in time and space, we have wings and are used to flying, but nowhere. We are not falling yet, but we are not moving either, we are frozen in anticipation of some kind of miracle. At least that's how I feel the world today... August, 2020
Collection
Available for sale
The series ‘Dreams about the North Sea’
by Lucy NychaiI explore the conditions of different materials and their connections with one another. This helps me to find a better solution for channelling and expressing my inner dialogue in crucial moments. On the one hand, it allows me to achieve a balance between over-responsibility and helplessness, and between anger and gratitude. On the other hand, I experience a pleasant sense of the moment through the observation of physical movements that I do not control.Each piece is an unexpected result in visual expression, but each is connected to my feelings and emotions in that particular moment through the colour palette. I always take control in the final movement of the liquid object to symbolically represent my role in turbulent circumstances. My acrylic ink experiments are a form of self-therapy, bringing me calmness and hope, and giving the spectator a chance to tune into an intrinsic release.Artworks description
I use a fine watercolour paper, which keeps water in a particular shape, which I put at the start of work. The shapes and colours appear from my deep meditation, an intrinsic reflection on my recent experience. The series ‘Dreams about the North Sea’ was a conscious reflection of my existence on the island surrounded by huge natural elements that divide and connect me with and from the unsafe world after I had spent the whole day on the seacoast of the North Sea.
Seacoast/ My blue room/ Whale.
| Title | Explication | Size/ Year/ material | ||
|---|---|---|---|---|
| Seacoast. Series Dreams about the North Sea | The ‘Seacoast’ is a capturing of the seaweeds' behaviour controlled by the waves. The dead leaves washed ashore by the waves are still beautiful, making the landscape fully alive. Interconnecting everything with everything is an amazing act of awareness of the lifecycle, which I was diving into. | 41,5 x 29,5 cm | ink on paper | 2024 |
| My blue room. Series Dreams about the North Sea | The ‘My blue room’ is an image of safe communication and, even more, of human beings as part of the ecosystem within the global water system. Blue-black spots is a dippest connection points surrounded by a cherished environment. We need to establish the relationship, and we need the entrance, and this is the blue room for the start. | 41,5 x 29,5 cm | ink on paper | 2024 |
| Whale. Series Dreams about the North Sea | The ‘Whale’ is observing the tumultuous elements, which stir thoughts of the grand. I've never seen whales, but in recognising the unity of all the aquatic realms on the planet, I gazed upon their habitat. | 41,5 x 29,5 cm | ink on paper | 2024 |
Black Sheep Project WIP
A personal investigation of my own traumatic experience of war.
This is my attempt to find a language of resilience and resistance.
2023-ongoing
In my project, I delve into the social postcolonial body, psycho-somatic processes, and the verbalisation of history for remembrance. I have a plethora of texts and facts ahead of me, which I will weave into a hempen tepestry regarding the war. It's about a man in war and about inclusion as a means of commemoration. It concerns the language of cultural heritage to document forbidden history. And certainly, it involves the black fleece, the black sheep in twisted narratives.
___________In the shadow of war and displacement, the concept of decolonisation takes on an intensely personal dimension. It is not only a dismantling of imperial systems, but a profound re-embodiment of self. Through my Black Sheep Project, I trace the arc of trauma, heritage, and resistance—an act of reclamation that weaves personal pain with collective memory.
War does not just tear apart cities; it splinters identity. For me, surviving war became synonymous with resisting erasure—not only of my body, but of my culture, language, and roots. In the Soviet and post-Soviet eras, Ukrainian identity was manipulated, rewritten, and often suppressed. Much like the "black sheep" in a flock, deviation from the homogenous norm was viewed as a flaw, not a strength. Yet now, it is this very difference—this refusal to conform—that has become a vehicle for cultural resistance and remembrance.

INTRO
Who am I?
I hail from the Ternopil region of Galicia, the western part of Ukraine. My formative years I coincided with the collapse of the Soviet Union, profoundly shaping my sense of identity. At the age of 9, I participated in the memorable Zluka chain, a significant event etched in my memory. On January 21, 1990, the symbolic Zluka chain "Ukrainian Wave" unfolded, stretching from Kyiv to Lviv, spanning 700 km. It symbolized the unity of Ukraine's eastern and western territories and marked the commemoration of the Act of Zluka. This event signaled the Ukrainian nation's defiance against the communist regime and its readiness to assert disagreement with the policies of the Communist Party, ultimately leading to the dissolution of the Soviet Union.Following this historic act, the Ukrainian Republic opted to secede from the Soviet Union, precipitating the downfall of the system. In schools, mandatory Russian language and literature studies ceased, making way for the introduction of Ukrainian history books and the exploration of Ukrainian folk songs and traditions. However, resources for studying Ukrainian culture were scarce, as decades of assimilation had led to the phenomenon of "sharovarshchyna," characterized by a diluted and superficial representation of Ukrainian traditions.Despite this, the Ternopil region preserved vibrant traditional embroidery, such as the Borshchiv shirt—a notable example of intangible cultural heritage in Ukraine.
This intricate embroidery has a legendary origin story: it is said that following a devastating Ottoman attack on nearby villages, then all the men were killed, the surviving women decided to don mourning attire, embroidering shirts solely with black threads. They vowed to mourn for seven generations, with the final generation born at the turn of the 20th century. By the 1930s, coloured threads and beads reappeared in embroidered shirts, marking the end of the mourning period.In recent years, I even had the opportunity to wear a Borshchiv shirt as part of a museum exhibit for a charitable photoshoot, reflecting my deep connection to and reverence for this rich cultural heritage.

The theory of generations and the theory of relativity
I've always desired a shirt like that, but I disliked the idea of replicating patterns... Each craftswoman embroidered her own design, making every shirt unique. Those seven generations, preserving their memories, created true masterpieces. Yet, generations shaped by the Soviet system could only copy, standardize, and simplify, erasing their own heritage in the process. Ten different stitches were reduced to cross-stitch (falsely believed to be traditional).Unfortunately, there are no written records about the time when the villages in the Ternopil Region were attacked. Similarly, there's little official confirmation about events in the 1940s, such as the forced resettlement of Ukrainians and Poles by the Soviet authorities.
Therefore, I became interested in WHEN the mass killings that led to the development of such a significant intangible cultural heritage could have occurred.According to contemporary theories, a generation spans about 20 years. So, seven generations would equal 140 years. Assuming the end of mourning is accurate, the attack likely happened around 1780-90.
In the years when the Russian-Turkish war was going on, Ternopil Oblast was part of the Austrian Empire. Around this time, the Russian Empire captured Volyn, which borders the region, and from 1809 to 1815, Ternopil Oblast was temporarily annexed by the Russian Empire due to the Napoleonic Wars.But this raises questions:
1) Why did the attackers kill all the men and leave the women? The Ottoman Empire traditionally carried out attacks for the sake of booty (young girls were taken to the "harem", young men and boys to the "yasir" (where they were raised to become soldiers for their army), why this time they only took all men were killed, all the women were left?
2) Could Ottoman troops have been in the area, considering the war line was farther south?
3) Might the attackers have been mistaken for Ottoman troops, given the historical context? In folk art, people called any attackers "Busurmans" (that meant Muslims, Ottomans), in connection with the history of previous centuries, when a lot of Ottoman invasions happened. Therefore, people could mistakenly identify those who attacked as Ottomans.
4) Could the legendary attack be similar to the suppression of rebels, which was common among peasants in Right-Bank Ukraine?So, it is difficult to understand who caused grief to the residents of Borshchiv. And given the fact that the generations could be shorter then, it is difficult to determine the exact chronology.
Additionally, the theory of relativity reminds us that the perception of time depends on the observer's frame of reference.This narrative reflects the broader history of Ukraine and my personal identity.
This is how you can talk about the history of Ukraine as a whole because books were re-written, documents were destroyed, oral transmissions were prohibited by order of various monarchs, and later the Communist Party, adjusted the history of Ukrainian territories to their advantage and their own history. Unnecessary and inconvenient facts were deleted.

Black sheep
"Borshchivska vyshyvanka" is a shirt made of thin, durable hemp cloth, with thick embroidery with black woollen threads.
In addition to the uncertain legend, art critics who are trying to find facts or logic added: that they probably embroidered only with black threads, because black sheep were kept in this area.And here I launched a new study.
According to the statements of biologists and breeders, Black fleece in sheep is a genetic accident, no one in natural conditions, without selection, could have predicted the appearance of a black lamb.
A black fleece is caused by a recessive gene, so if a white ram and a white ewe are each heterozygous for black, about one in four of their lambs will be black. In most white sheep breeds, only a few white sheep are heterozygous for black, so black lambs are usually much rarer than this.
Therefore, this theory is also relative.I came across interesting facts, for example, that in European countries - the black sheep - has a symbolic meaning, precisely because of its rarity and unexpectedness. In the Bible, a black sheep is called a bad sign, so faithful Christians were afraid of this disaster. Over time, the black sheep ceased to have a sacred meaning, but it was still a nuisance for farmers, because the black fleece cannot be redyed. Although, following certain orders of repetition or the algorithm of the appearance of a black lamb in a flock, it was used for counting, where one black sheep meant a hundred.
A phraseology has appeared among the people, which describes an extraordinary personality in his circle, mostly in a negative sense. Over time, a certain definition appeared in psychology for people who can identify themselves with their environment. The term has typically been given negative implications, implying waywardness.
I also came across a story about Princess Diana's jumper with "black sheep" that was recently auctioned.My country "Black Sheep"
Correction and equalization, destruction of extraordinary personalities lasted for half a century during the times of Soviet Ukraine, as evidenced by historical events such as the Shot Renaissance, the Holodomor, and total Russification in education. But during the 30 years of relative independence, the number of "black sheep" increased, no one destroyed them, they were only moderated. Ukrainians have grown out of post-Soviet "clothes" and restored their "memetic nation", which is tied to the land on which it exists. Multinational, diverse and united. No one expected such a Ukraine, and it became a "black sheep" with the beginning of the war for the world, which is strongly connected with the Russian economy.There are many conversations about Ukraine on all social networks, reading thousands of comments you can find different things. At the beginning of the war, there was a lot of admiration for the courage of a small state, but today the advice is simply "Lie down and the war will stop."But this is not even happening because of the war, because there are more than a hundred wars in the world now, but because it is happening in the centre of the European continent and prevents stable economies from living in comfortable conditions.
I understand how the citizens of various distant states think - just surrender and the war will stop. This is the main goal of all sofa peacekeepers. But no one realizes that giving up means going back to the 1790s. Under the conditions of the occupation, maybe I personally will not be killed, the chances are 50/50, and I will not be sold into sexual slavery, because I am not young, but I will be in prison, or I will be forever IN EXILE. And that's what keeps me from giving up.
Mourning
In the spring of 2023, during a conference in Birmingham focusing on solidarity with Ukraine, I experienced my first emotional trauma after losing my home. A professor from the London College of Arts, originally from the former Yugoslavia, advised us - Ukrainian artists - to begin collaborating closely with Russian organizations in cultural projects as part of a process of reconciliation.I was overcome with fury but struggled to articulate my thoughts in my limited English. Just the day before, friend of mine artist Svitlana had shared heartbreaking news - her father losing both legs near Bakhmut. IIn the same time the death of the brother of my classmate, artist and teacher of Design department in Art College Oksana. Pasha, a biker and designer, still recovering from a nearly severed hand suffered during the capture of Kyiv. The video blogger Oleksandr, were learning to walk again with prostheses, while Kyiv artist Bohdan was rehabilitating a crippled spine, and Lviv artist Roman had been wounded in the arm. Mamai had disappeared from communication.
Turning my anger into something constructive, I delved into the various stitches of Borschiv embroidery, creating my own ornament as a symbol of mourning for the lives lost, body parts severed, and souls scarred. Embroidering black silhouettes of bodies, hands, and feet on coarse hemp canvas using synthetic wool, I painted my grief onto the canvases, disregarding conventional norms.This practice has provided ample room for reflection, research, and self-discovery, liberating my identity from the constraints of relativistic theories.

Stalker
All my investigation is slightly weird and intuitive. Onese I take a little experiment with the Google Translate app.
These are the remains of wool formed during the thread change during the embroidery process. Algorithms equate everything that is incomprehensible to something familiar, but even here everything depends on the angle from which the fixation takes place.
"I'm relaxing" - it was true, stitching quite calm practice.
"Slate" - nothing meant to me at the time and didn't point to anything close to my research.
"Sloshing" - I really wandered around something important.
The next step in progress...
Embroidery brings me calmness and consciousness. I gees, I found my personal identity. It's a crucial achievement for me.

When you look into your past, sifting through the half-forgotten names of your ancestors, claiming the identity of the place where you grew up or where you could have grown up, searching for the roots of your belonging to collective sorrow, sifting through facts, you stumble upon the ancient wisdom that ‘each creates a unique pattern,’ while we spend our lives learning to reproduce it.
And when it seems that everything has already been invented, said, and repeated, you shrink to the proportions of your own body and realize the countless coincidences that have made it unique, the experiences lived with it, which are also unique, a unique set of data of which it is the bearer.

Personal pattern
Embroidery on hessian, using two of the ten types of Borshchiv stitches.
Created during my travels in 2023-2024, Ternopil, Berlin, and Hexham.My next expression has been in progress since July 2025...

Resettlement - the pop-up residence
Lite-Haus Gallery, Berlin, Germany
January-February 2024
Resettlement is a pop-up art residency programme designed to rethink the conditions and challenges faced by migrants in their journeys. This long-term project took place at Lite-Haus Gallery + Projectarium, where I became the curator of one of the rooms, organising group practice and the final exhibition with six local and resettled artists.
We worked with a specific set of materials and tools to create new artworks. During the sessions, we discussed each participant’s experience in this shared laboratory. Altogether, we held five creative sessions with the artists and organised two public events during the course of the exhibition.
Each session centred around a different theme—home, travel, neighbourhood, autonomy, and dignity—which we explored through conversation and collaborative practice. The gallery rooms became a cooperative studio space for myself and six Berlin-based artists: four Ukrainians and two artists originally from Turkey and Iran.At the exhibition titled “Autonomy and Dignity”, we presented the artists’ works alongside their personal reflections on the process. In addition, we co-authored a Common Statement on dignity and autonomy. During the public events, we invited the audience to contribute their own thoughts to this collective statement, creating a shared space of dialogue and expression.
"It's the G and F", a multilinguistic performance by Ariana Emminghaus
As part of the "Resettlement" project, a multilingual performance "It's the G and F// Das ist das A und D// Це Н and И" took place
(in German/ English/ Ukrainian)
The author of the texts is Ariana Eminhaus (German-Iranian writer and artist). Native speakers Debbie Davies (New York/Berlin) and Marta Pogorila (Odesa/Kherson) took part in the performance.
This performance is an opportunity to feel yourself in a multilingual environment, to answer your own questions
What is actually normal?
What is crazy?
What is a family?
What am I doing here?
Am I in the right place?
AUTONOMY AND DIGNITY
Unfortunately, questions of autonomy and dignity arise in the exacerbation of conflicts when they become unbearable, and the pursuit of these definitions becomes the goal of the struggle, becoming catalysts for their development through resistance and the manifestation of resilience.Oftentimes, this leads to mass migrations and searches for refuge in societies where autonomy and dignity are accessible. Often, the loss of autonomy and dignity occurs through silence, and collective consent.Therefore, we want to talk about it again, regardless of how much has already been said. We must discuss it as long as it remains relevant.Our exhibition represents the results of the "Resettlement" pop-up art residence. We have invited artists with personal migration stories to share and illuminate significant narratives concerning the well-being and dignity of individuals who have experienced or are presently undergoing forced or voluntary migration.We had 5 meetings with discussions and making visual statements. It was like art therapy and at the same time, we worked hard.
AUTONOMY+DIGNITY
Artworks

COMMON STATEMENT
Anton / Antonina / Ariana / Dmytro / Lucy / Maria / SinemWe amalgamate diverse voices and affirmations, addressing questions for which answers elude simplicity. We juxtapose illusions, dreams, realities, and possibilities, cherishing fond memories of home while seeking new tranquil, secure, and welcoming spaces where we can sleep peacefully, roam freely, and engage in safe interactions. For those experienced in migration, home transcends mere recollection; it embodies a profound sense of belonging.
We transcend distances to evolve into improved versions of ourselves, flowing away from or staying with illusion and utopias. Immersing ourselves in new environments, we yearn for acceptance amidst our differences, boundaries, and needs, eschewing shallow discourse in favour of profound exploration.
We recognize Dignity as an inherent aspect of our being, forever striving to uphold it. Autonomy, to us, represents the independent awareness of our desires, empowered by resources that facilitate choice.

Maria Lutsak - HomeI am a graphic artist from Kyiv, Ukraine, based in Berlin.After the full-scale invasion of russia into Ukraine, while staying in Berlin I often reflect in my art on the theme of finding my place, the meaning of home and the importance of relationships with loved ones.During the art residency "Resettlement", talking about home, I came up with the idea to use the nest as a symbol of home, and to depict it in three stages - the first image represents the peaceful and quiet time "before", the second - the turning point of invasion and forced relocation and the third object is the home in my current understanding. It is fragile and shaky, not bound to a particular plane and can be anywhere. Over time I realized that home is first of all the love of family and friends, which is always with you inside, no matter how far you are from your "physical" home. In this nest I wove phrases from letters in which my friends and relatives write me how much they love and support me, it makes me feel at home wherever I am.For works on paper I chose granulating watercolor as a material, which created an expressive chaotic background for the object, for the nest - paper strips to emphasize its fragility.
Sinem Vardar - This is a whirling dreamQueer feminist artist and writer from Izmir/Turkey, based in Berlin'This is a whirling dream' is a collection of mine that represents the endeavor to dive into a unified, unbounded, and fluid field to capture traces of the raw state of existence that I define as home.All four works in this collection emerged instinctively, without any plan or image in my mind. The dreamlike and fluid state of the figures and colors was achieved through engaging natural objects as active co-creators of the paintings: stamping with plants, throwing color and water with different kinds of shells, allowing color, water, plants, and shells to actively participate in the painting process. What emerges at the end is a footprint of a brief moment, capturing the feeling of being at home - a cotton layer with the faint memory of a fluid state of coexistence.My works celebrate life and nature, expressing the experience of pure love and joy. Simultaneously, they portray a deep sorrow and grief over the loss of home and family, as well as the destruction of the earth, our collective home, by human greed and violence.

Ariana Emminghaus - "Das ist das A und D" / "It‘s the G and F"I am a writer and performer based in Berlin.The collection of texts "Das ist das A und D" / "It‘s the G and F" talks about my experiences living in a multicultural family. It focuses particularly on my Iranian mother's experiences of foreignness in comparison to my own. Central questions are: What is actually normal? What is crazy? What is family? What am I doing here? Am I in the right place?The text is written matter-of-factly, stylistically contrasting the highly emotional situations and complex feelings that are being discussed. They take place in a psychiatric ward, on the train and on a living room couch. They talk about family dynamics, alienation and even murder. All instances, even the extreme ones, especially the extreme ones, are directly based on my and our reality between the years of 2017 and 2024. The work is autofictional.The visualization was achieved by creating a 3D model using XPS, glue, linen, my handwriting, a gold color, print and a mirror.Like the texts, being read by myself in the audio loop, the physical object demonstrates the multidimensional nature of perception and the complexity of the human mind. The eyes, a photograph of my own eyes, are a direct reference to the line in the text that says: "My eyes have opening hours too.""Das ist das A und D" / "It‘s the G and F" is a collection of memories, an incomplete representation of a family and the desire to be seen, to be heard – as more than one or several letters.

Antonina Savitska - IMPACTMade during the “Resettlement” Art Residency.This project is unfolding an experience of being resettle to Germany due the fact of the beginning of the Russian - Ukrainian war.In this series of photographs I have identified the main factors of the environment in which I grew up that determine the state of my existence. Language as the intellectual filling and style of thinking, nutrition as the physical filling of my body, climate as the body's ability to interact with the environment. Despite defining my autonomy, these factors create a feeling of distance, discomfort and disorientation in the new culture and country, boosts an internal conflict between expectation and reality.This work was created to point out the difficulties people face with unexpected, forced relocation.Method of implementation: Analog Photography with Digital Processing
Berlin, Germany 2024

Dmytro Goncharenko - Scape of changesI am a mixed-media artist and curator based in Berlin.During the “Resettlement” Art Residency was made an audiovisual installation under the title "scape of changes" as dedication to memory: how it works with the landscapes and changes, how to determine the native space if it exists only in memories.The photos were taken in 2009 as a memory of my native place – Yampil, Lyman district, Donetsk area. The lens was broken and it gave the natural glitched effect.Occasionally these were the last photos well known from my childhood area.After all the years from the start of the war 2014 and high scale war from 2022 the landscape was changed, the fields are mined, bullet-riddled forest and broken living houses.Now the area is in the deep front line, and many locals had to leave their homes, so the village became almost abandoned and last at least in memory.The changes of a landscape in remains of memory is a theme of visual and sound reflections.Soundscapes by Olha Havrylenko and Dmytro GoncharenkoBerlin, 2024
Lucy Nychai - The series “Resettlement. Berlin. 2024”
I’m a curator and multidisciplinary artist,
Before the war, I lived in Kyiv.
I worked with an artist-in-residence program in the west of Ukraine and with community research in the east of Ukraine. Now, I live and work between the UK and Ukraine, and sometimes I visit Berlin.
I work with the topics of memory and commemoration, sustainable ecosystems, and site-specific projects, and study ethical issues of digital art. The last 10 years, my art practice has focused on the impact of the Russian invasion of Ukraine. In my art practice, I use different mediums like video, mural, sculpting, drawing, Indian Ink and embroidery.
Over the past three years, I've channelled my emotions through the uncontrolled flow of ink on paper. This practice has become my way of training myself to maintain clarity of mind in diverse circumstances—to learn to accept life and death around me without placing blame on myself, especially amidst the challenges posed by COVID-19 and war.
When I arrived in Berlin in January 2024, I immersed myself in studying my surroundings. Initially, I explored Neukölln, Kronsberg, and Tempelhof alone. As I delved deeper, I began discussing my discoveries, such as Treptower and Görlitzer, with others. Along the way, I encountered the juxtaposition of nature's beauty and societal complexities. Rather than attempting to change a world that isn't mine to alter, I returned to honing my skills in Indian ink.
My improvised coloured forms are supplemented with chaotic mycelium, which symbolises mutual influences and relationships in society and also maintains a certain level of humidity.The series, 2024:
“Autonomy” A5, Ink on paper
“Sacrifice” A5, Ink on paper
“Absorption” A5, Ink on paper
“Feud” A5, Ink on paper
Anton Vertwen - My Bequests For YouBerlin, originally from Kyiv, Ukraine- I draw simple, silly forms and I like writing texts.
- I strive to create projects that are fun and entertaining yet have an interesting story/concept if a viewer cares enough to pause and explore a bit.
- The idea comes first, without it it’s just pretty pictures.
- I think today it is very hard to catch and keep viewer’s attention, no one’s gonna read your 12 books of text.
- I don’t have an art education, and I’m a bit stupid so I try to make my art simple and approachable.
- I mostly do digital art, but lately try to do more physical art, but it’s hard and messy (but I guess you can see that).
- Humor is my favorite tool, without it my artwork doesn’t feel right.
- I think that if after interacting with my art a person is feeling that they had a good time - my job is done. No changing lives or worlds here.
- Next time I’ll try to do something with music and games and make my art more interactive.Today I’m presenting my most recent project, which was in the making since last year - “My Bequests For You”

Contact
Let's collaborate!
My interests are global:)
Physical mobility available to me today is the UK, the EU, Ukraine, and the USA